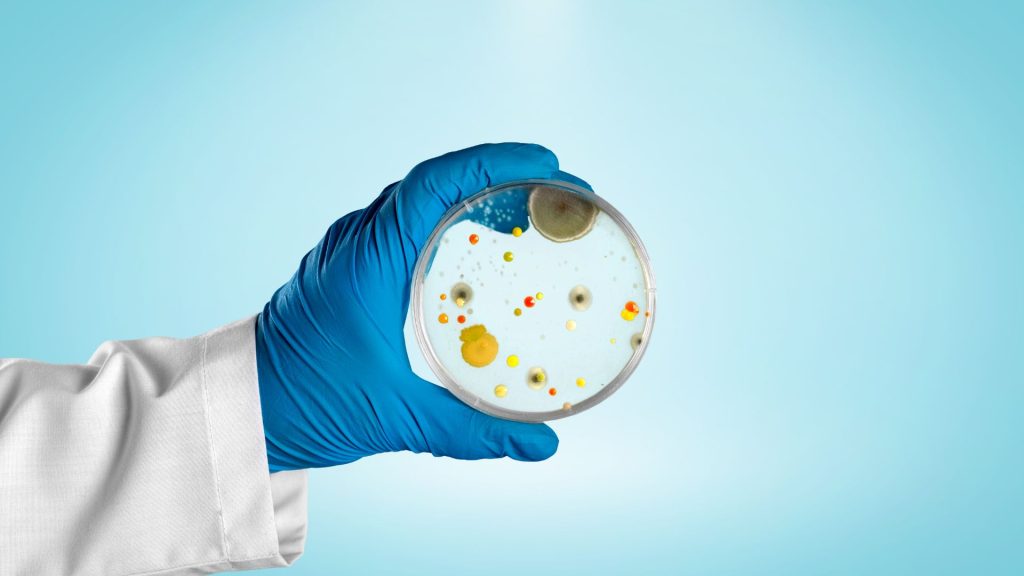

Revisiones Ginecológicas
Revisiones Ginecológicas Las revisiones ginecológicas son exámenes médicos que se realizan para evaluar la salud de los órganos reproductivos femeninos, incluyendo el útero, los ovarios y la vagina. Las revisiones ginecológicas se recomiendan para todas las mujeres a partir de los 21 años o cuando comiencen a tener relaciones sexuales. Las revisiones ginecológicas suelen incluir […]
Revisiones Ginecológicas Leer más »